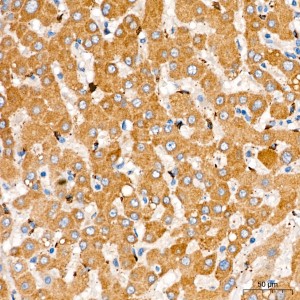
KD-Validated CYB5R3 Rabbit mAb (20 μl)

KD-Validated CYB5R3 Rabbit mAb (20 μl)
| Reactivity: | Human, Mouse, Rat |
| Applications: | WB, IHC, IF/IC, ELISA |
| Host Species: | Rabbit |
| Isotype: | IgG |
| Clonality: | Monoclonal antibody |
| Gene Name: | cytochrome b5 reductase 3 |
| Gene Symbol: | CYB5R3 |
| Synonyms: | B5R; DIA1 |
| Gene ID: | 1727 |
| UniProt ID: | P00387 |
| Clone ID: | 8S4W1 |
| Immunogen: | Recombinant Protein corresponding to a sequence within amino acids 27-301 of human CYB5R3(NP_000389.1). |
| Dilution: | WB 1:2000-1:8000; IHC 1:200-1:800; IF/IC 1:200-1:800 |
| Purification Method: | Affinity purification |
| Concentration: | 2.21 mg/ml |
| Buffer: | PBS with 0.05% proclin300, 0.05% BSA, 50% glycerol, pH7.3. |
| Storage: | Store at -20°C. Avoid freeze / thaw cycles. |
| Documents: | Manual-CYB5R3 monoclonal antibody |
Background
This gene encodes cytochrome b5 reductase, which includes a membrane-bound form in somatic cells (anchored in the endoplasmic reticulum, mitochondrial and other membranes) and a soluble form in erythrocytes. The membrane-bound form exists mainly on the cytoplasmic side of the endoplasmic reticulum and functions in desaturation and elongation of fatty acids, in cholesterol biosynthesis, and in drug metabolism. The erythrocyte form is located in a soluble fraction of circulating erythrocytes and is involved in methemoglobin reduction. The membrane-bound form has both membrane-binding and catalytic domains, while the soluble form has only the catalytic domain. Alternate splicing results in multiple transcript variants. Mutations in this gene cause methemoglobinemias.
Images
 | Western blot analysis of lysates from Rat liver using [KD Validated] CYB5R3 Rabbit mAb (A25842) at 1:2200 dilution incubated overnight at 4℃. Secondary antibody: HRP-conjugated Goat anti-Rabbit IgG (H+L) (AS014) at 1:10000 dilution. Lysates/proteins: 25 μg per lane. Blocking buffer: 3% nonfat dry milk in TBST. Detection: ECL Basic Kit (RM00020). Exposure time: 8s. |
 | Western blot analysis of various lysates using [KD Validated] CYB5R3 Rabbit mAb (A25842) at 1:2200 dilution incubated overnight at 4℃. Secondary antibody: HRP-conjugated Goat anti-Rabbit IgG (H+L) (AS014) at 1:10000 dilution. Lysates/proteins: 25 μg per lane. Blocking buffer: 3% nonfat dry milk in TBST. Detection: ECL Basic Kit (RM00020). Exposure time: 30s. |
 | Western blot analysis of lysates from wild type (WT) and CYB5R3 knockdown (KD) HeLa cells using [KD Validated] CYB5R3 Rabbit mAb (A25842) at 1:2200 dilution incubated overnight at 4℃. Secondary antibody: HRP-conjugated Goat anti-Rabbit IgG (H+L) (AS014) at 1:10000 dilution. Lysates/proteins: 25 μg per lane. Blocking buffer: 3% nonfat dry milk in TBST. Detection: ECL Basic Kit (RM00020). Exposure time: 30s. |
 | Immunohistochemistry analysis of paraffin-embedded Human liver tissue using [KD Validated] CYB5R3 Rabbit mAb (A25842) at a dilution of 1:200 (40x lens). High pressure antigen retrieval performed with 0.01M Citrate Bufferr (pH 6.0) prior to IHC staining. |
 | Immunohistochemistry analysis of paraffin-embedded Mouse liver tissue using [KD Validated] CYB5R3 Rabbit mAb (A25842) at a dilution of 1:200 (40x lens). High pressure antigen retrieval performed with 0.01M Citrate Bufferr (pH 6.0) prior to IHC staining. |
 | Immunohistochemistry analysis of paraffin-embedded Rat liver tissue using [KD Validated] CYB5R3 Rabbit mAb (A25842) at a dilution of 1:200 (40x lens). High pressure antigen retrieval performed with 0.01M Citrate Bufferr (pH 6.0) prior to IHC staining. |
 | Confocal imaging of HeLa cells using [KD Validated] CYB5R3 Rabbit mAb (A25842, dilution 1:200) followed by a further incubation with Cy3 Goat Anti-Rabbit IgG (H+L) (AS007, dilution 1:500) (Red). The cells were counterstained with α-Tubulin Mouse mAb (AC012, dilution 1:400) followed by incubation with ABflo® 488-conjugated Goat Anti-Mouse IgG (H+L) Ab (AS076, dilution 1:500) (Green). DAPI was used for nuclear staining (Blue). Objective: 100x. |
 | Confocal imaging of NIH/3T3 cells using [KD Validated] CYB5R3 Rabbit mAb (A25842, dilution 1:200) followed by a further incubation with Cy3 Goat Anti-Rabbit IgG (H+L) (AS007, dilution 1:500) (Red). The cells were counterstained with α-Tubulin Mouse mAb (AC012, dilution 1:400) followed by incubation with ABflo® 488-conjugated Goat Anti-Mouse IgG (H+L) Ab (AS076, dilution 1:500) (Green). DAPI was used for nuclear staining (Blue). Objective: 100x. |
You may also be interested in: